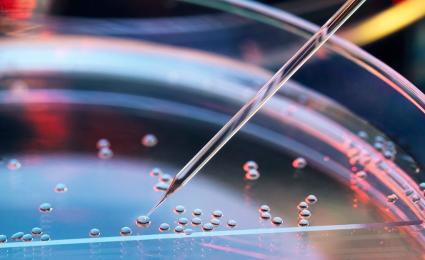
Global Pharma Study 2025 – how to thrive in times of radical uncertainty

Roland Berger advises pharma, MedTech and insurance companies on how to master the challenges of the future.


Pharma at the intelligence frontier
By Thilo Kaltenbach, Michael Baur and Stephan Fath
Creating value from AI in the pharmaceutical industry
Artificial intelligence (AI) is advancing at a remarkable speed, driving a shift that no industry can avoid – least of all pharmaceuticals. The technology is continuously gathering new momentum, opening up fresh possibilities and expanding what machines can do. Already, the impact on productivity can be seen, with AI reshaping how work gets done and pushing beyond what once seemed realistic. This leaves industry leaders facing an urgent question: How can they turn this momentum into measurable value and redefine how the industry operates in the age of intelligence?

Over the past decade, pharma companies have built a solid digital base. Early efforts centered on smarter use of data and moving toward digital trial workflows, supported by gradual advances in manufacturing. The industry then began expanding digital more broadly, with decentralized trials and machine learning tools. Now, AI is deepening its role in discovery and starting to influence both supply decisions and quality control. The next step will draw these advances together into a connected ecosystem where patient digital twins support real-time treatment adjustment.
"For pharma leaders, creating value from AI is no longer an option - it is a key strategic imperative."
The impact of AI
AI is set to drive deep change in the years ahead. Currently, its strongest foothold is in research, but momentum is building in development, clinical work and operations, with automation and data-driven tools already beginning to raise performance and reduce delays. As pilot projects mature, AI is entering routine use, supporting tasks such as forecasting and planning, while also improving process control. Companies view this shift as essential because it strengthens margins in a market shaped by rising costs and increasing pressure to deliver productivity gains.
One of the reasons margins are so important is that they fund future innovation. Across the industry, companies are working to contain production costs, and AI is easing this pressure by sharpening cost visibility and tightening maintenance routines. In R&D, it helps teams identify stronger scientific options earlier, enabling efforts to shift toward ideas with clearer promise. In commercial functions, AI also improves the focus of field activity and raises the quality of decisions in support roles.
Use cases abound
The use cases for AI are many and varied, covering all parts of the value chain. In research, AI is able to review biomedical literature and help design experiments. In development, it flags protocol risks and analyzes patient populations. Product supply teams use AI for batch release optimization or supply chain simulations that reveal vulnerabilities earlier. Medical teams use AI to prepare scientific responses more efficiently and to support virtual inquiry handling. Commercial groups benefit from reimbursement analytics or contract management tools. With such a wide range of options, the challenge is choosing where AI creates the most value.
Ensuring success – with Roland Berger’s Perform.AI
Delivering meaningful value from AI requires a structured approach that is still flexible enough to be adapted to each company’s needs. The first step is to quickly assess and prioritize use cases, supported by fast evaluation of external solutions. Lean operating models with well-integrated processes help secure early returns, backed by clear financial targets and decision frameworks that keep initiatives on track. Companies also need to unlock existing talent and enable teams to work across functions, while ensuring legal, regulatory and IT partners stay closely involved. Roland Berger’s Perform.AI approach brings these elements together – mobilizing business, technology and people through a tailored blueprint and coordinated implementation.
Roland Berger’s uniquely effective support combines strategic insight with strong technical capabilities and an extensive partner network. We assist companies across the pharmaceutical industry, guiding them through AI transformation and helping them choose relevant use cases. Our job? To shape the changes that organizations really need.
Want to explore how AI can strengthen your business, drive your innovation capacity and protect your performance in a fast-shifting market? Download the full study here for more insights.
Register now to access the full study. Furthermore, you get regular news and updates directly in your inbox.